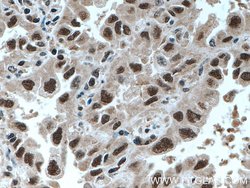
UBE3A Rabbit anti-Human, Mouse, Rat, Polyclonal, Proteintech 20 &mu;L | Buy Online | Proteintech | Fisher Scientific
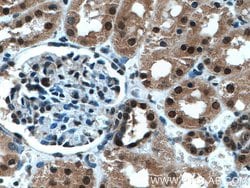
UBE3A Rabbit anti-Human, Mouse, Rat, Polyclonal, Proteintech 20 &mu;L | Buy Online | Proteintech | Fisher Scientific

missing translation for 'onlineSavingsMsg'
Learn More
Learn More
Description
The E6-associated protein (E6-AP/UBE3A), a 100a protein, was originally identified as an ubiquitin-protein ligase (E3), in the presence of the E6 protein from human papillomavirus types 16 and 18. E6-AP has also been shown to function as a coactivator of steroid receptor-dependent transcriptional activity. Recent data indicate that the ubiquitin-protein ligase function of E6-AP is dispensable for its ability to coactivate nuclear hormone receptors, showing that E6-AP possesses two separable independent functions, as both a coactivator and a ubiquitin-protein ligase.
Specifications
Specifications
| Antigen | UBE3A |
| Applications | Immunohistochemistry (Paraffin), Immunofluorescence, Immunocytochemistry, Immunoprecipitation, Western Blot |
| Classification | Polyclonal |
| Concentration | 0.33 mg/mL |
| Conjugate | Unconjugated |
| Formulation | PBS with 50% glycerol and 0.02% sodium azide; pH 7.3 |
| Gene | UBE3A |
| Gene Accession No. | O08759, Q05086 |
| Gene Alias | ANCR, AS, E6 AP, E6AP, E6AP ubiquitin protein ligase, EPVE6AP, HPVE6A, UBE3A, ubiquitin protein ligase E3A |
| Gene Symbols | Ube3a |
| Show More |
Product Title
By clicking Submit, you acknowledge that you may be contacted by Fisher Scientific in regards to the feedback you have provided in this form. We will not share your information for any other purposes. All contact information provided shall also be maintained in accordance with our Privacy Policy.
Spot an opportunity for improvement?